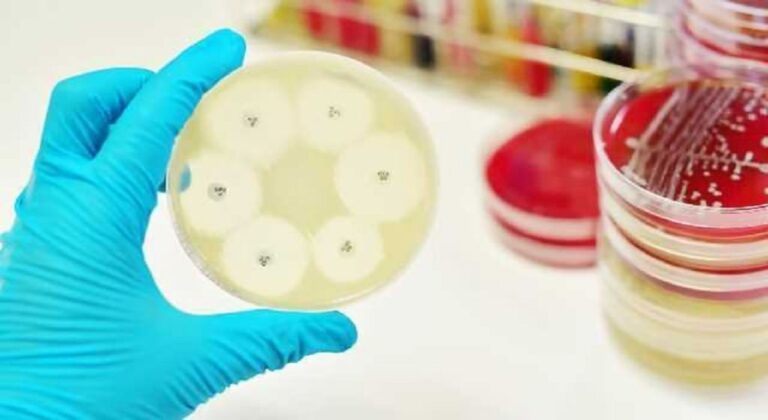
Νοσοκομειακές Λοιμώξεις: Οκτώ παθογόνοι μικροοργανισμοί και ένα εμβόλιο

Νέα έρευνα δείχνει ότι έως και 1 στους 4 εφήβους με αυτισμό μπορεί να μην έχει διαγνωστεί. Αυτή η εντυπωσιακή μελέτη ρίχνει φως στον επιπολασμό του αυτισμού μεταξύ των εφήβων, υπογραμμίζοντας την ανάγκη για βελτιωμένη ευαισθητοποίηση και έγκαιρη διάγνωση.

Αυτισμός
Ο επικεφαλής ερευνητής, Walter Zahorodny, αναπληρωτής καθηγητής στην Ιατρική Σχολή Rutgers New Jersey, τόνισε ότι ο αυτισμός είναι πιο διαδεδομένος από ό,τι συνήθως υποτίθεται. Αυτή η μελέτη είναι πρωτοποριακή καθώς είναι η πρώτη πληθυσμιακή εξέταση δημόσιας υγείας για τον επιπολασμό του αυτισμού μεταξύ των εφήβων.
Για τη διεξαγωγή της έρευνας, η ομάδα ανέλυσε τα σχολικά αρχεία και τα αρχεία υγείας σχεδόν 4.900 16χρονων που κατοικούσαν σε τέσσερις κομητείες του Νιου Τζέρσεϊ του βορρά το 2014. Στην αρχική ανασκόπηση, 1.365 περιπτώσεις απαιτούσαν περαιτέρω έρευνα. Τελικά, 560 επιβεβαιώθηκαν ότι είχαν διαταραχή του φάσματος του αυτισμού (ΔΑΦ).
Αυτό που είναι ιδιαίτερα ανησυχητικό είναι ότι 384 από αυτούς τους εφήβους είχαν διαγνωστεί με αυτισμό σε ηλικία 8 ετών, αλλά 176 πληρούσαν τα διαγνωστικά κριτήρια για αυτισμό στα 16. Με άλλα λόγια, 1 στα 55 παιδιά στις κομητείες του Νιου Τζέρσεϊ που μελετήθηκαν είχαν αυτισμό, με ένα το τέταρτο από αυτά παρέμειναν αδιάγνωστα μέχρι αυτή τη μελέτη.
Επιπλέον, η μελέτη αποκάλυψε ότι 3 στους 5 εφήβους με αυτισμό είχαν επίσης μια άλλη νευροψυχιατρική διαταραχή, συνηθέστερα διαταραχή ελλειμματικής προσοχής/υπερκινητικότητας (ADHD).
Ο Walter Zahorodny πιστεύει ότι αυτά τα ευρήματα είναι πιθανώς αντιπροσωπευτικά άλλων περιοχών στις Ηνωμένες Πολιτείες, τονίζοντας ότι τα υψηλά ποσοστά αυτισμού δεν περιορίζονται στα παιδιά αλλά επηρεάζουν και τους εφήβους.
Ο Δρ Andrew Adesman, επικεφαλής αναπτυξιακής και συμπεριφορικής παιδιατρικής στο Cohen Children’s Medical Center της Νέας Υόρκης, επεσήμανε ότι οι αριθμοί μπορεί να είναι ακόμη υψηλότεροι σήμερα λόγω του αυξημένου επιπολασμού του αυτισμού από το 2014.
Η μελέτη αποκάλυψε επίσης παραλλαγές στα ποσοστά αυτισμού ανάλογα με το φύλο, την εθνικότητα και την οικονομική κατάσταση. Ο αυτισμός ήταν πιο συχνός στα αγόρια, με 1 στα 55 να ταυτίζονται με ΔΑΦ σε σύγκριση με 1 στα 172 κορίτσια. Επιπλέον, ο αυτισμός ήταν δύο φορές πιο διαδεδομένος στους εφήβους από νοικοκυριά υψηλότερου εισοδήματος σε σύγκριση με τα άτομα με χαμηλότερο εισόδημα. Υπήρχαν επίσης διαφορές μεταξύ φυλετικών και εθνοτικών ομάδων, με τον αυτισμό να είναι πιο κοινός στους λευκούς εφήβους από τους μαύρους ή τους ισπανόφωνους εφήβους.
Ωστόσο, μια πανεθνική μελέτη που δημοσιεύθηκε τον Μάρτιο ανέφερε αύξηση στα ποσοστά αυτισμού από 1 στους 44 το 2018 σε 1 στους 36 το 2020. Οι συγγραφείς απέδωσαν αυτή την αύξηση σε βελτιωμένες υπηρεσίες προσυμπτωματικού ελέγχου και αυτισμού, σημειώνοντας ότι οι διαγνώσεις αυτισμού αυξάνονταν για τα μαύρα και τα ισπανόφωνα παιδιά , σηματοδοτώντας ένα θετικό βήμα προς την ίση πρόσβαση σε υποστήριξη και υπηρεσίες.

Ο Walter Zahorodny και η ομάδα του σχεδιάζουν να συνεχίσουν τη μελέτη αυτής της ομάδας εφήβων, ελπίζοντας να αποκτήσουν μια βαθύτερη κατανόηση του τρόπου με τον οποίο εξελίσσεται ο αυτισμός στους νεαρούς ενήλικες και πώς να παρέχουν την κατάλληλη φροντίδα και παρέμβαση στα επηρεαζόμενα άτομα. Αυτά τα ευρήματα υπογραμμίζουν τη σημασία της έγκαιρης διάγνωσης, της ευαισθητοποίησης και της υποστήριξης για άτομα στο φάσμα του αυτισμού.